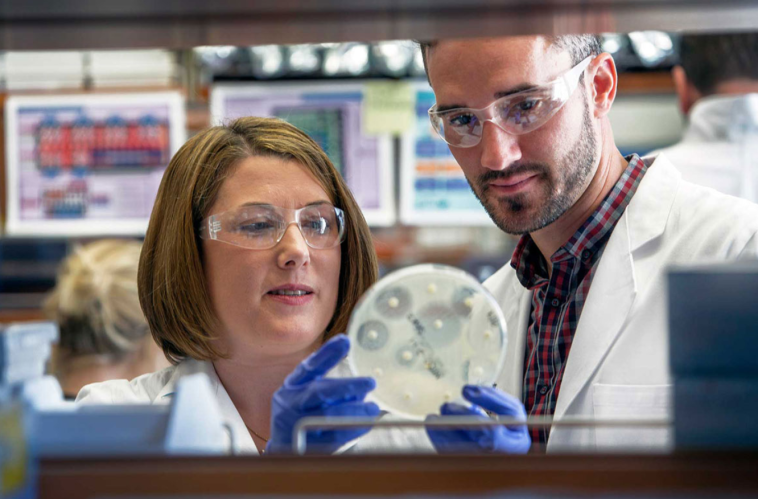

Ο σταφυλόκοκκος είναι ένα βακτήριο που συνήθως υπάρχει στη φυσιολογική μικροβιοκοινότητα του δέρματος, χωρίς να προκαλεί προβλήματα. Ωστόσο, υπό συγκεκριμένες συνθήκες μπορεί να αυξηθεί η αντιστοιχία του και να επιφέρει νόσο.
- Πάτα ΕΔΩ για τη συνέχεια

GIPHY App Key not set. Please check settings